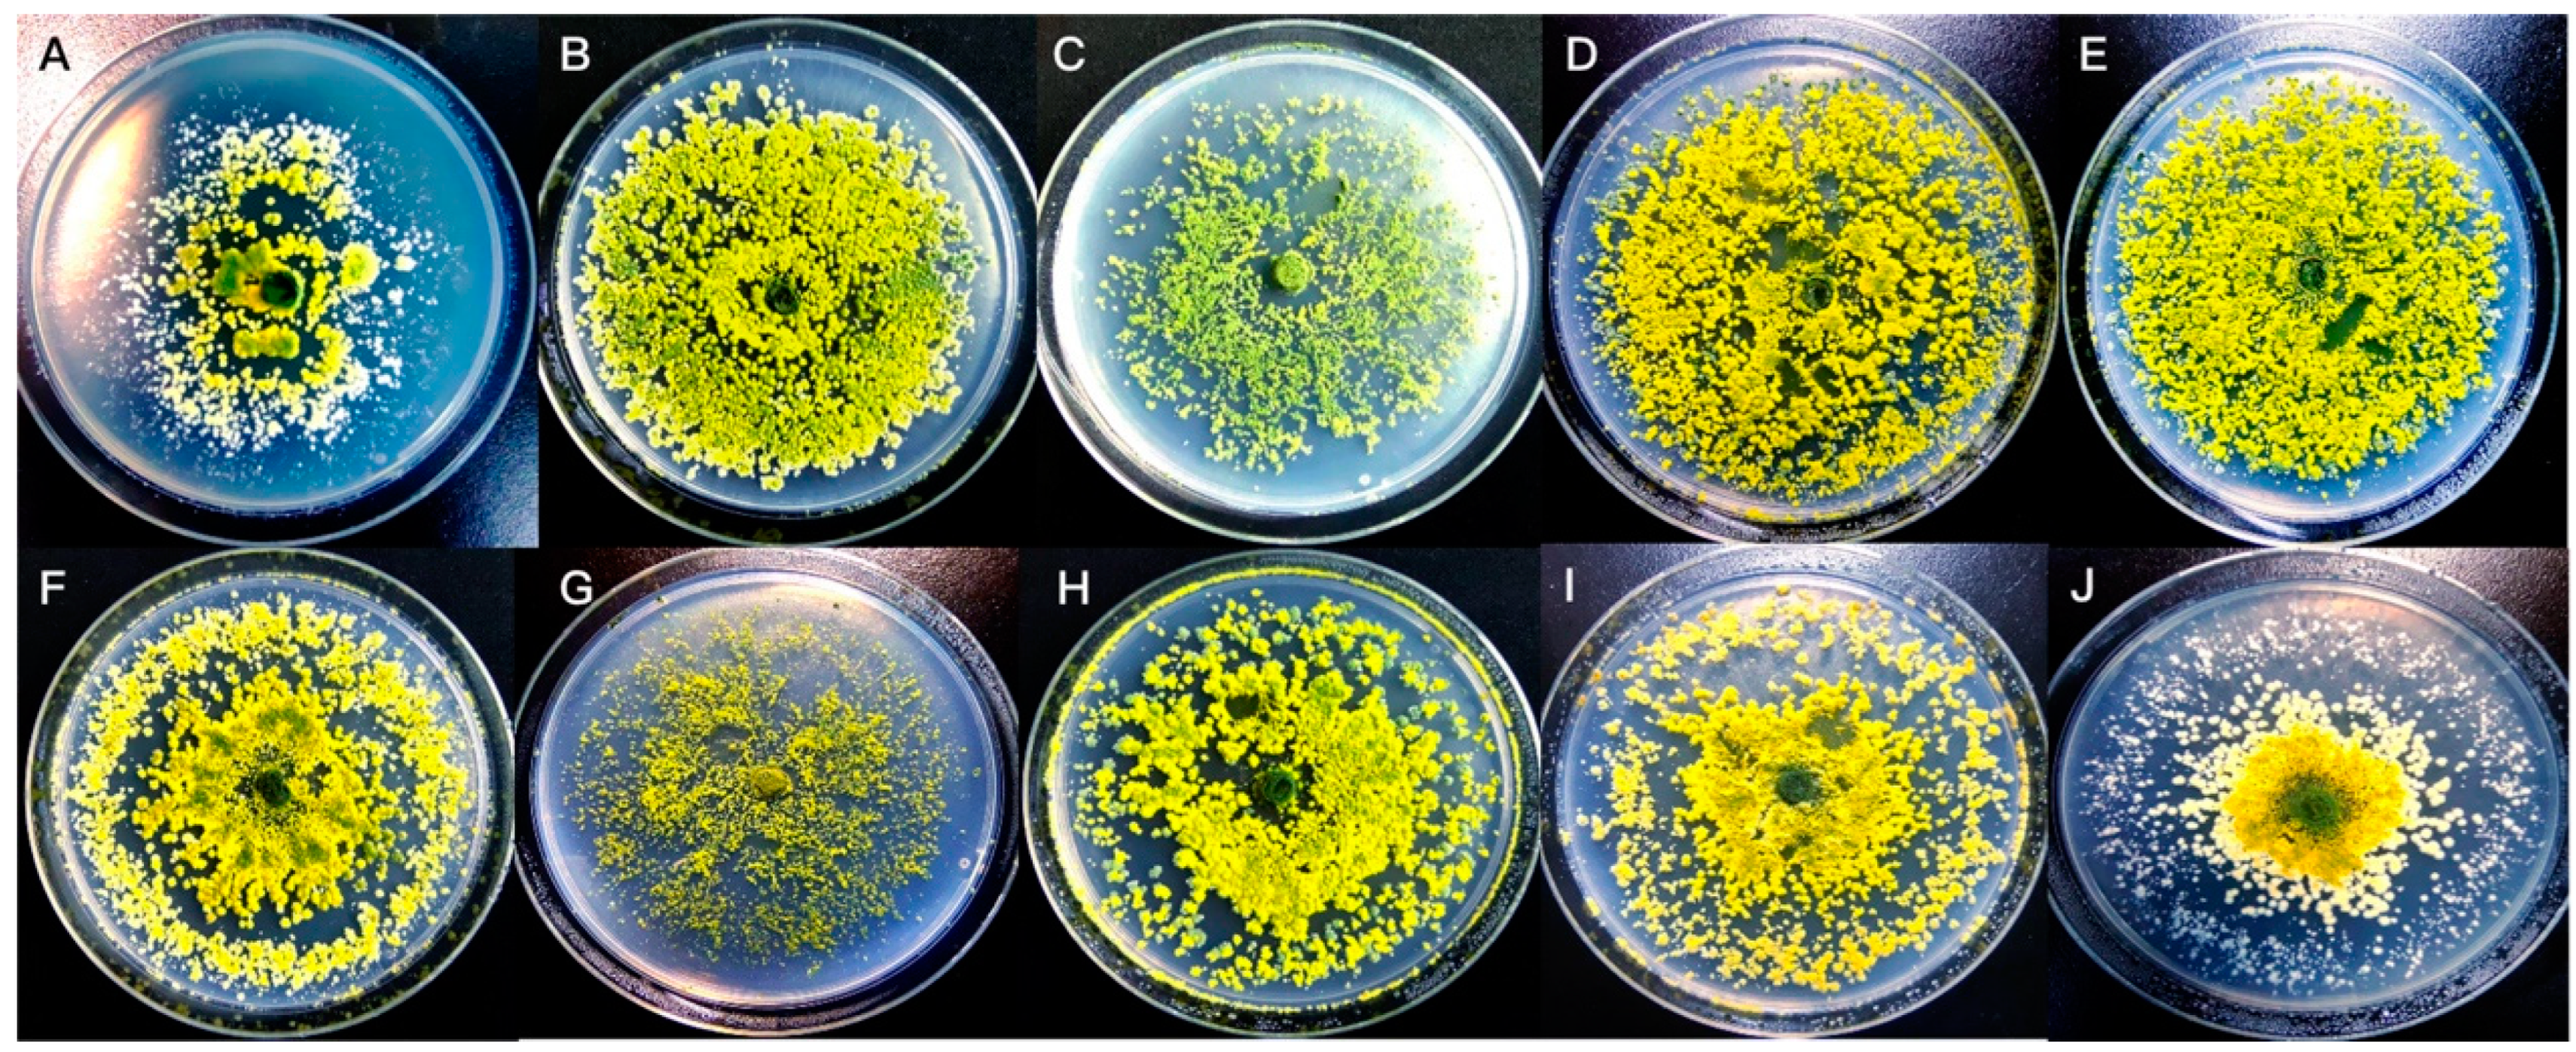
Fermentation 11 00181 g005

Proteomic and Mechanistic Insights into the Efficiency of Atmospheric and Room-Temperature Plasma Mutagenesis-Driven Bioconversion of Corn Stover by Trichoderma longibrachiatum
Abstract
1. Introduction
2. Materials and Methods
2.1. Microorganisms and Cultivation Conditions
2.1.1. Fungal Strains and Maintenance
2.1.2. Inoculum Preparation
2.2. Solid-State Fermentation
2.2.1. Substrate Preparation and Pretreatment
2.2.2. Fermentation Setup and Parameters
2.3. ARTP Mutagenesis
2.3.1. ARTP Apparatus Settings and Operation
2.3.2. Spore Preparation for Mutagenesis
2.3.3. Mutagenesis Procedure and Survival Rate Determination
2.3.4. Mutant Preservation and Stability Assessment
2.4. Screening of Mutants
2.4.1. Primary Screening on CMC-Na Plates
2.4.2. Secondary Screening in Shake Flask Cultures
2.4.3. Tertiary Screening Under SSF
2.5. Analytical Methods
2.5.1. Enzyme Extraction
2.5.2. Enzyme Activity Assays
2.5.3. Compositional Analysis of Lignocellulosic Substrate
2.5.4. Protein and Peptide Quantification
2.5.5. Morphological Analysis of Fungal Colonies
2.6. Proteomic Analysis
2.7. Statistical Analysis
3. Results and Discussion
3.1. Comparative Evaluation of Lignocellulolytic Capabilities Among Selected Fungal Genera During Corn Stover SSF
3.1.1. Temporal Dynamics and Strain-Specific Patterns of Enzyme Production
3.1.2. Strain-Specific Enzymatic Profiles and Comparative Analysis of Lignocellulose Degradation
3.1.3. Quantitative Assessment of Structural Component Degradation and Strain-Specific Deconstruction Patterns
3.1.4. Preliminary Determination of T. longibrachiatum as the Preferred Candidate
3.2. Parametric Optimization of ARTP Mutagenesis and Screening for Enhanced Lignocellulolytic Mutants
3.2.1. Dose–Response Kinetics of Spore Viability Under ARTP Plasma Treatment
3.2.2. Primary Screening of Enhanced Cellulolytic Mutants Through Hydrolytic Zone Analysis
3.2.3. Secondary Screening and Comprehensive Analysis of Selected Mutant Strains
3.2.4. Colony Morphology Differentiation of T. longibrachiatum Cellulolytic Mutants
3.3. Comparative Evaluation of Mutant Strains Under SSF
3.4. Proteomic Analysis Reveals Molecular Basis for Enhanced Cellulolytic Performance in ARTP-Generated Mutant
3.4.1. Characterization of Proteome Architecture and Strain-Specific Expression Patterns
3.4.2. Differential Proteome Analysis Reveals Coordinated Metabolic and Regulatory Adaptations Underlying Enhanced Lignocellulolytic Capacity
3.5. Comparative Characterization of TL-MU07
4. Conclusions
Author Contributions
Funding
Institutional Review Board Statement
Informed Consent Statement
Data Availability Statement
Conflicts of Interest
References
- Mujtaba, M.; Fernandes Fraceto, L.; Fazeli, M.; Mukherjee, S.; Savassa, S.M.; Araujo de Medeiros, G.; do Espírito Santo Pereira, A.; Mancini, S.D.; Lipponen, J.; Vilaplana, F. Lignocellulosic biomass from agricultural waste to the circular economy: A review with focus on biofuels, biocomposites and bioplastics. J. Clean. Prod. 2023, 402, 136815. [Google Scholar] [CrossRef]
- Babu, S.; Singh Rathore, S.; Singh, R.; Kumar, S.; Singh, V.K.; Yadav, S.K.; Yadav, V.; Raj, R.; Yadav, D.; Shekhawat, K.; et al. Exploring agricultural waste biomass for energy, food and feed production and pollution mitigation: A review. Bioresour. Technol. 2022, 360, 127566. [Google Scholar] [CrossRef]
- Enahoro, D.; Lannerstad, M.; Pfeifer, C.; Dominguez-Salas, P. Contributions of livestock-derived foods to nutrient supply under changing demand in low- and middle-income countries. Glob. Food Secur. 2018, 19, 1–10. [Google Scholar] [CrossRef]
- Di Fidio, N.; Carmassi, L.; Kasmiarti, G.; Fulignati, S.; Licursi, D.; Raspolli Galletti, A.M.; Antonetti, C. Chemical and enzymatic hydrolysis of waste wheat bran to sugars and their simultaneous biocatalytic conversion to valuable carotenoids and lipids. Catal. Today 2024, 442, 114941. [Google Scholar] [CrossRef]
- Di Fidio, N.; Tozzi, F.; Martinelli, M.; Licursi, D.; Fulignati, S.; Antonetti, C.; Raspolli Galletti, A.M. Sustainable Valorisation and Efficient Downstream Processing of Giant Reed by High-Pressure Carbon Dioxide Pretreatment. ChemPlusChem 2022, 87, e202200189. [Google Scholar] [CrossRef]
- Guo, H.; Chang, J.; Yin, Q.; Wang, P.; Lu, M.; Wang, X.; Dang, X. Effect of the combined physical and chemical treatments with microbial fermentation on corn straw degradation. Bioresour. Technol. 2013, 148, 361–365. [Google Scholar] [CrossRef]
- Kim, J.S.; Lee, Y.Y.; Kim, T.H. A review on alkaline pretreatment technology for bioconversion of lignocellulosic biomass. Bioresour. Technol. 2016, 199, 42–48. [Google Scholar] [CrossRef]
- D’Orsi, R.; Di Fidio, N.; Antonetti, C.; Raspolli Galletti, A.M.; Operamolla, A. Isolation of Pure Lignin and Highly Digestible Cellulose from Defatted and Steam-Exploded Cynara cardunculus. ACS Sustain. Chem. Eng. 2023, 11, 1875–1887. [Google Scholar] [CrossRef] [PubMed]
- Soccol, C.R.; Costa, E.S.F.D.; Letti, L.A.J.; Karp, S.G.; Woiciechowski, A.L.; Vandenberghe, L.P.D.S. Recent developments and innovations in solid state fermentation. Biotechnol. Res. Innov. 2017, 1, 52–71. [Google Scholar] [CrossRef]
- Rayhane, H.; Josiane, M.; Gregoria, M.; Yiannis, K.; Nathalie, D.; Ahmed, M.; Sevastianos, R. From flasks to single used bioreactor: Scale-up of solid state fermentation process for metabolites and conidia production by Trichoderma asperellum. J. Environ. Manag. 2019, 252, 109496. [Google Scholar] [CrossRef]
- Bamidele, M.O.; Bamikale, M.B.; Cárdenas-Hernández, E.; Bamidele, M.A.; Castillo-Olvera, G.; Sandoval-Cortes, J.; Aguilar, C.N. Bioengineering in Solid-State Fermentation for next sustainable food bioprocessing. Next Sustain. 2025, 6, 100105. [Google Scholar] [CrossRef]
- Mattedi, A.; Sabbi, E.; Farda, B.; Djebaili, R.; Mitra, D.; Ercole, C.; Cacchio, P.; Del Gallo, M.; Pellegrini, M. Solid-State Fermentation: Applications and Future Perspectives for Biostimulant and Biopesticides Production. Microorganisms 2023, 11, 1408. [Google Scholar] [CrossRef] [PubMed]
- Kshirsagar, S.; Waghmare, P.; Saratale, G.; Saratale, R.; Kurade, M.; Jeon, B.H.; Govindwar, S. Composition of Synthesized Cellulolytic Enzymes Varied with the Usage of Agricultural Substrates and Microorganisms. Appl. Biochem. Biotechnol. 2020, 191, 1695–1710. [Google Scholar] [CrossRef] [PubMed]
- Li, W.; Zhao, L.; He, X. Degradation potential of different lignocellulosic residues by Trichoderma longibrachiatum and Trichoderma afroharzianum under solid state fermentation. Process Biochem. 2022, 112, 6–17. [Google Scholar] [CrossRef]
- Duarte, E.R.; Maia, H.A.R.; Freitas, C.E.S.; da Silva Alves, J.M.; Valério, H.M.; Cota, J. Hydrolysis of lignocellulosic forages by Trichoderma longibrachiatum isolate from bovine rumen. Biocatal. Agric. Biotechnol. 2021, 36, 102135. [Google Scholar] [CrossRef]
- Viniegra-González, G.; Favela-Torres, E.; Aguilar, C.N.; Rómero-Gomez, S.d.J.; Díaz-Godínez, G.; Augur, C. Advantages of fungal enzyme production in solid state over liquid fermentation systems. Biochem. Eng. J. 2003, 13, 157–167. [Google Scholar] [CrossRef]
- Bose, J.L. Chemical and UV mutagenesis. In The Genetic Manipulation of Staphylococci: Methods and Protocols; Humana Press: New York, NY, USA, 2016; pp. 111–115. [Google Scholar] [CrossRef]
- Li, D.; Shen, J.; Ding, Q.; Wu, J.; Chen, X. Recent progress of atmospheric and room-temperature plasma as a new and promising mutagenesis technology. Cell Biochem. Funct. 2024, 42, e3991. [Google Scholar] [CrossRef]
- Zhang, X.; Zhang, X.F.; Li, H.P.; Wang, L.Y.; Zhang, C.; Xing, X.H.; Bao, C.Y. Atmospheric and room temperature plasma (ARTP) as a new powerful mutagenesis tool. Appl. Microbiol. Biotechnol. 2014, 98, 5387–5396. [Google Scholar] [CrossRef]
- Zhang, X.; Zhang, C.; Zhou, Q.Q.; Zhang, X.F.; Wang, L.Y.; Chang, H.B.; Li, H.P.; Oda, Y.; Xing, X.H. Quantitative evaluation of DNA damage and mutation rate by atmospheric and room-temperature plasma (ARTP) and conventional mutagenesis. Appl. Microbiol. Biotechnol. 2015, 99, 5639–5646. [Google Scholar] [CrossRef]
- Zou, Z.; Zhao, Y.; Zhang, T.; Xu, J.; He, A.; Deng, Y. Efficient isolation and characterization of a cellulase hyperproducing mutant strain of Trichoderma reesei. J. Microbiol. Biotechnol. 2018, 28, 1473–1481. [Google Scholar] [CrossRef]
- Gao, F.; Hao, Z.; Sun, X.; Qin, L.; Zhao, T.; Liu, W.; Luo, H.; Yao, B.; Su, X. A versatile system for fast screening and isolation of Trichoderma reesei cellulase hyperproducers based on DsRed and fluorescence-assisted cell sorting. Biotechnol. Biofuels 2018, 11, 261. [Google Scholar] [CrossRef]
- Peng, Z.-Q.; Li, C.; Lin, Y.; Wu, S.-S.; Gan, L.-H.; Liu, J.; Yang, S.-L.; Zeng, X.-H.; Lin, L. Cellulase production and efficient saccharification of biomass by a new mutant Trichoderma afroharzianum MEA-12. Biotechnol. Biofuels 2021, 14, 219. [Google Scholar] [CrossRef]
- Chilakamarry, C.R.; Sakinah, A.M.M.; Zularisam, A.W.; Sirohi, R.; Khilji, I.A.; Ahmad, N.; Pandey, A. Advances in solid-state fermentation for bioconversion of agricultural wastes to value-added products: Opportunities and challenges. Bioresour. Technol. 2022, 343, 126065. [Google Scholar] [CrossRef]
- Vélez-Mercado, M.I.; Talavera-Caro, A.G.; Escobedo-Uribe, K.M.; Sánchez-Muñoz, S.; Luévanos-Escareño, M.P.; Hernández-Terán, F.; Alvarado, A.; Balagurusamy, N. Bioconversion of lignocellulosic biomass into value added products under anaerobic conditions: Insight into proteomic studies. Int. J. Mol. Sci. 2021, 22, 12249. [Google Scholar] [CrossRef] [PubMed]
- Fang, H.; Zhao, C.; Li, Y.; Song, Y.; Wu, Y.; Song, X.; Wu, J.; Yang, L. Multi-omics study on the mixed culture of Trichoderma reesei and Aspergillus niger with improved lignocellulase production. Biomass Bioenergy 2024, 190, 107374. [Google Scholar] [CrossRef]
- Sluiter, A.; Ruiz, R.; Scarlata, C.; Sluiter, J.; Templeton, D. Determination of Extractives in Biomass; Laboratory Analytical Procedure (LAP). Natl. Renew. Energy Lab. 2008, 7, 2005. [Google Scholar]
- Kong, X.; He, A.; Zhao, J.; Wu, H.; Ma, J.; Wei, C.; Jin, W.; Jiang, M. Efficient acetone–butanol–ethanol (ABE) production by a butanol-tolerant mutant of Clostridium beijerinckii in a fermentation–pervaporation coupled process. Biochem. Eng. J. 2016, 105, 90–96. [Google Scholar] [CrossRef]
- Song, Z.; Jiang, Y.; Chen, C.; Ding, C.; Chen, H. Effect of Plasma-Activated Water on the Cellulase-Producing Strain Aspergillus niger A32. J. Fungi 2024, 10, 568. [Google Scholar] [CrossRef]
- El-Shishtawy, R.M.; Mohamed, S.A.; Asiri, A.M.; Gomaa, A.-b.M.; Ibrahim, I.H.; Al-Talhi, H.A. Solid fermentation of wheat bran for hydrolytic enzymes production and saccharification content by a local isolate Bacillus megatherium. BMC Biotechnol. 2014, 14, 29. [Google Scholar] [CrossRef]
- Ghose, T.K. Measurement of cellulase activities. Pure Appl. Chem. 1987, 59, 257–268. [Google Scholar] [CrossRef]
- Rubeena, M.; Neethu, K.; Sajith, S.; Sreedevi, S.; Priji, P.; Unni, K.N.; Josh, M.K.S.; Jisha, V.N.; Pradeep, S.; Benjamin, S. Lignocellulolytic activities of a novel strain of Trichoderma harzianum. Adv. Biosci. Biotechnol. 2013, 4, 214–221. [Google Scholar] [CrossRef]
- Törrönen, A.; Mach, R.L.; Messner, R.; Gonzalez, R.; Kalkkinen, N.; Harkki, A.; Kubicek, C.P. The Two Major Xylanases from Trichoderma Reesei: Characterization of Both Enzymes and Genes. Bio/technology 1992, 10, 1461–1465. [Google Scholar] [CrossRef] [PubMed]
- Jin, X.; Song, J.; Ma, J.; Liu, G.-Q. Thermostable β-xylosidase from Aspergillus fumigatus: Purification, characterization and potential application in lignocellulose bioethanol production. Renew. Energy 2020, 155, 1425–1431. [Google Scholar] [CrossRef]
- Kameshwar, A.K.S.; Qin, W. Qualitative and Quantitative Methods for Isolation and Characterization of Lignin-Modifying Enzymes Secreted by Microorganisms. BioEnergy Res. 2017, 10, 248–266. [Google Scholar] [CrossRef]
- Samarasinghe, M.B.; Larsen, M.; Johansen, M.; Waldemar, P.; Weisbjerg, M.R. Effects of shredding on silage density and fermentation quality. Grass Forage Sci. 2019, 74, 244–253. [Google Scholar] [CrossRef]
- Elgar, D.F.; Hill, J.P.; Holroyd, S.E.; Peddie, G.S. Comparison of analytical methods for measuring protein content of whey protein products and investigation of influences on nitrogen conversion factors. Int. J. Dairy. Technol. 2020, 73, 790–794. [Google Scholar] [CrossRef]
- Sterling, C.; Crouch, R.; Russell, D.J.; Calderón, A.I. 1H-NMR Quantification of Major Saccharides in Açaí Raw Materials: A Comparison of the Internal Standard Methodology with the Absolute Intensity qNMR Method. Phytochem. Anal. 2013, 24, 631–637. [Google Scholar] [CrossRef]
- Reiter, L.; Rinner, O.; Picotti, P.; Hüttenhain, R.; Beck, M.; Brusniak, M.Y.; Hengartner, M.O.; Aebersold, R. mProphet: Automated data processing and statistical validation for large-scale SRM experiments. Nat. Methods 2011, 8, 430–435. [Google Scholar] [CrossRef]
- Yin, Y.; Mao, X.; Yang, J.; Chen, X.; Mao, F.; Xu, Y. dbCAN: A web resource for automated carbohydrate-active enzyme annotation. Nucleic Acids Res. 2012, 40, W445–W451. [Google Scholar] [CrossRef]
- Miao, Y.; Chen, X.; Li, T.; Zhu, H.; Tang, S.; Liu, D.; Shen, Q. Proteomic analysis reflects an environmental alkalinization-coupled pH-dependent mechanism of regulating lignocellulases in Trichoderma guizhouense NJAU4742. Biotechnol. Biofuels 2020, 13, 6. [Google Scholar] [CrossRef]
- Ren, F.; Wu, F.; Wu, X.; Bao, T.; Jie, Y.; Gao, L. Fungal systems for lignocellulose deconstruction: From enzymatic mechanisms to hydrolysis optimization. GCB Bioenergy 2024, 16, e13130. [Google Scholar] [CrossRef]
- Ren, K.; Wang, Q.; Hu, M.; Chen, Y.; Xing, R.; You, J.; Xu, M.; Zhang, X.; Rao, Z. Research Progress on the Effect of Autolysis to Bacillus subtilis Fermentation Bioprocess. Fermentation 2022, 8, 685. [Google Scholar] [CrossRef]
- La Grange, D.C.; Pretorius, I.S.; Claeyssens, M.; van Zyl, W.H. Degradation of xylan to D-xylose by recombinant Saccharomyces cerevisiae coexpressing the Aspergillus niger beta-xylosidase (xlnD) and the Trichoderma reesei xylanase II (xyn2) genes. Appl. Environ. Microbiol. 2001, 67, 5512–5519. [Google Scholar] [CrossRef]
- Li, L.; Peng, C.; Yu, K.; Tang, Y.; Lin, Y.; Li, L.; Ni, H.; Li, Q. Expression of β-xylosidase An-xyl from Aspergillus niger and characterization of its xylose tolerance. Sheng Wu Gong. Cheng Xue Bao 2023, 39, 4593–4607. [Google Scholar] [CrossRef] [PubMed]
- Almeida, D.A.; Horta, M.A.C.; Ferreira Filho, J.A.; Murad, N.F.; de Souza, A.P. The synergistic actions of hydrolytic genes reveal the mechanism of Trichoderma harzianum for cellulose degradation. J. Biotechnol. 2021, 334, 1–10. [Google Scholar] [CrossRef]
- Van Dyk, J.S.; Pletschke, B.I. A review of lignocellulose bioconversion using enzymatic hydrolysis and synergistic cooperation between enzymes—Factors affecting enzymes, conversion and synergy. Biotechnol. Adv. 2012, 30, 1458–1480. [Google Scholar] [CrossRef]
- Yuan, W.; Gong, Z.; Wang, G.; Zhou, W.; Liu, Y.; Wang, X.; Zhao, M. Alkaline organosolv pretreatment of corn stover for enhancing the enzymatic digestibility. Bioresour. Technol. 2018, 265, 464–470. [Google Scholar] [CrossRef] [PubMed]
- Lu, X.; Zhao, Y.; Li, F.; Liu, P. Active polysaccharides from Lentinula edodes and Pleurotus ostreatus by addition of corn straw and xylosma sawdust through solid-state fermentation. Int. J. Biol. Macromol. 2023, 228, 647–658. [Google Scholar] [CrossRef]
- Zhu, Y.S.; Zhang, H.B.; Zhang, Y.L.; Huang, F. Lignocellulose degradation, enzyme production and protein enrichment by Trametes versicolor during solid-state fermentation of corn stover. Afr. J. Biotechnol. 2011, 10, 9182–9192. [Google Scholar] [CrossRef]
- Chu, X.; Awasthi, M.K.; Liu, Y.; Cheng, Q.; Qu, J.; Sun, Y. Studies on the degradation of corn straw by combined bacterial cultures. Bioresour. Technol. 2021, 320, 124174. [Google Scholar] [CrossRef]
- Burlacu, A.; Israel-Roming, F.; Cornea, C.P. Depolymerization of kraft lignin with laccase and peroxidase: A review. Sci. Bull. Ser. F Biotechnol. 2018, 22, 172–179. [Google Scholar]
- Branzei, D.; Foiani, M. Regulation of DNA repair throughout the cell cycle. Nat. Rev. Mol. Cell Biol. 2008, 9, 297–308. [Google Scholar] [CrossRef]
- Dexheimer, T.S. DNA Repair Pathways and Mechanisms; Springer: Dordrecht, The Netherlands, 2013. [Google Scholar] [CrossRef]
- Li, X.-H.; Yang, H.-J.; Roy, B.; Park, E.Y.; Jiang, L.-J.; Wang, D.; Miao, Y.-G. Enhanced cellulase production of the Trichoderma viride mutated by microwave and ultraviolet. Microbiol. Res. 2010, 165, 190–198. [Google Scholar] [CrossRef]
- Eyre-Walker, A.; Keightley, P.D. The distribution of fitness effects of new mutations. Nat. Rev. Genet. 2007, 8, 610. [Google Scholar] [CrossRef] [PubMed]
- Booker, T.R. Inferring parameters of the distribution of fitness effects of new mutations when beneficial mutations are strongly advantageous and rare. G3 Genes Genomes Genet. 2020, 10, 2317–2326. [Google Scholar] [CrossRef] [PubMed]
- Tani, S.; Kawaguchi, T.; Kobayashi, T. Complex regulation of hydrolytic enzyme genes for cellulosic biomass degradation in filamentous fungi. Appl. Microbiol. Biotechnol. 2014, 98, 4829–4837. [Google Scholar] [CrossRef]
- Mattam, A.J.; Chaudhari, Y.B.; Velankar, H.R. Factors regulating cellulolytic gene expression in filamentous fungi: An overview. Microb. Cell Factories 2022, 21, 44. [Google Scholar] [CrossRef]
- Zhou, J.; Zhu, P.; Hu, X.; Lu, H.; Yu, Y. Improved secretory expression of lignocellulolytic enzymes in Kluyveromyces marxianus by promoter and signal sequence engineering. Biotechnol. Biofuels 2018, 11, 235. [Google Scholar] [CrossRef]
- Yao, G.; Li, Z.; Gao, L.; Wu, R.; Kan, Q.; Liu, G.; Qu, Y. Redesigning the regulatory pathway to enhance cellulase production in Penicillium oxalicum. Biotechnol. Biofuels 2015, 8, 71. [Google Scholar] [CrossRef]
- Fletcher, M. Transcription factor binding site affinity and the link to phenotype. Nat. Genet. 2024, 56, 357. [Google Scholar] [CrossRef]
- Pinarbasi, E.S.; Karamyshev, A.L.; Tikhonova, E.B.; Wu, I.H.; Hudson, H.; Thomas, P.J. Pathogenic Signal Sequence Mutations in Progranulin Disrupt SRP Interactions Required for mRNA Stability. Cell Rep. 2018, 23, 2844–2851. [Google Scholar] [CrossRef] [PubMed]
- Liu, X.; Yao, X.; Tsang, S.Y. Post-Translational Modification and Natural Mutation of TRPC Channels. Cells 2020, 9, 135. [Google Scholar] [CrossRef] [PubMed]
- Bellucci, M.; De Marchis, F.; Pompa, A. The endoplasmic reticulum is a hub to sort proteins toward unconventional traffic pathways and endosymbiotic organelles. J. Exp. Bot. 2017, 69, 7–20. [Google Scholar] [CrossRef] [PubMed]
- Dimou, E.; Nickel, W. Unconventional mechanisms of eukaryotic protein secretion. Curr. Biol. 2018, 28, R406–R410. [Google Scholar] [CrossRef]
- Kim, S.S. A multi-omics approach to assess production of the valuable peptides and amino acids in porcine blood protein hydrolysate. LWT 2022, 163, 113593. [Google Scholar] [CrossRef]
- Rogers, L.D.; Overall, C.M. Proteolytic post-translational modification of proteins: Proteomic tools and methodology. Mol. Cell Proteom. 2013, 12, 3532–3542. [Google Scholar] [CrossRef]
- Lu, Z.; Chen, Z.; Liu, Y.; Hua, X.; Gao, C.; Liu, J. Morphological Engineering of Filamentous Fungi: Research Progress and Perspectives. J. Microbiol. Biotechnol. 2024, 34, 1197–1205. [Google Scholar] [CrossRef]
- Asis, A.; Shahriar, S.A.; Naher, L.; Saallah, S.; Fatihah, H.N.N.; Kumar, V.; Siddiquee, S. Identification patterns of Trichoderma strains using morphological characteristics, phylogenetic analyses and lignocellulolytic activities. Mol. Biol. Rep. 2021, 48, 3285–3301. [Google Scholar] [CrossRef]
- Zhang, Q.; Lin, J.; Yan, J.; Miao, R.; Feng, R.; Gan, Y.; Gan, B. Enhanced Heat Resistance in Morchella eximia by Atmospheric and Room Temperature Plasma. Microorganisms 2024, 12, 518. [Google Scholar] [CrossRef]
- Zhang, N.; Jiang, Y.; Sun, Y.J.; Jiang, J.C.; Tong, Y.J. Breeding of a thermostable xylanase-producing strain of Myceliophthora thermophila by atmospheric room temperature plasma (ARTP) mutagenesis. Front. Bioeng. Biotechnol. 2022, 10, 1095323. [Google Scholar] [CrossRef]
- Yoon, L.W.; Ang, T.N.; Ngoh, G.C.; Chua, A.S.M. Fungal solid-state fermentation and various methods of enhancement in cellulase production. Biomass Bioenergy 2014, 67, 319–338. [Google Scholar] [CrossRef]
- Hölker, U.; Höfer, M.; Lenz, J. Biotechnological advantages of laboratory-scale solid-state fermentation with fungi. Appl. Microbiol. Biotechnol. 2004, 64, 175–186. [Google Scholar] [CrossRef] [PubMed]
- Singhania, R.R.; Patel, A.K.; Soccol, C.R.; Pandey, A. Recent advances in solid-state fermentation. Biochem. Eng. J. 2009, 44, 13–18. [Google Scholar] [CrossRef]
- Khoury, P.E.; Salameh, C.; Younes, S.; Awad, A.; Khalaf, R.A. Phenotypic and Cell Wall Proteomic Characterization of a DDR48 Mutant Candida albicans Strain. J. Microbiol. Biotechnol. 2019, 29, 1806–1816. [Google Scholar] [CrossRef]
- Shimizu, M.; Yuda, N.; Nakamura, T.; Tanaka, H.; Wariishi, H. Metabolic regulation at the tricarboxylic acid and glyoxylate cycles of the lignin-degrading basidiomycete Phanerochaete chrysosporium against exogenous addition of vanillin. Proteomics 2010, 5, 3919–3931. [Google Scholar] [CrossRef]
- Goodson, H.V.; Jonasson, E.M. Microtubules and Microtubule-Associated Proteins. Cold Spring Harb. Perspect. Biol. 2018, 10, a022608. [Google Scholar] [CrossRef] [PubMed]
- Marmorstein, R.; Carey, M.; Ptashne, M.; Harrison, S.C. DNA recognition by GAL4: Structure of a protein-DNA complex. Nature 1992, 356, 408–414. [Google Scholar] [CrossRef]
- Vincent, O.; Carlson, M. Sip4, a Snf1 kinase-dependent transcriptional activator, binds to the carbon source-responsive element of gluconeogenic genes. EMBO J. 1998, 17, 7002–7008. [Google Scholar] [CrossRef]
- Seo, J.-A.; Guan, Y.; Yu, J.-H. FluG-Dependent Asexual Development in Aspergillus nidulans Occurs via Derepression. Genetics 2006, 172, 1535–1544. [Google Scholar] [CrossRef]
- Duran; A. Fungal cell wall biogenesis: Building a dynamic interface with the environment. Microbiology 2004, 150, 3099. [Google Scholar] [CrossRef]
- Gohlke, S.; Heine, D.; Schmitz, H.-P.; Merzendorfer, H. Septin-associated protein kinase Gin4 affects localization and phosphorylation of Chs4, the regulatory subunit of the Baker’s yeast chitin synthase III complex. Fungal Genet. Biol. 2018, 117, 11–20. [Google Scholar] [CrossRef]
- Li, Y.-K.; Zhang, Y.-M.; Dai, G.-Y.; Chen, Y.-L.; Chen, D.-K.; Yao, N. Sphingolipid remodeling in the plasma membrane is essential for osmotic stress tolerance in Arabidopsis. Plant Physiol. 2025, 197, kiaf031. [Google Scholar] [CrossRef] [PubMed]
- Sierra, M.I.; Wright, M.H.; Nash, P.D. AMSH Interacts with ESCRT-0 to Regulate the Stability and Trafficking of CXCR4. J. Biol. Chem. 2010, 285, 13990–14004. [Google Scholar] [CrossRef]
- Smith, P.J.; Wang, H.T.; York, W.S.; Peña, M.J.; Urbanowicz, B.R. Designer biomass for next-generation biorefineries: Leveraging recent insights into xylan structure and biosynthesis. Biotechnol. Biofuels 2017, 10, 286. [Google Scholar] [CrossRef]
- Lee, D.K.; Ahn, S.; Cho, H.Y.; Yun, H.Y.; Park, J.H.; Lim, J.; Lee, J.; Kwon, S.W. Metabolic response induced by parasitic plant-fungus interactions hinder amino sugar and nucleotide sugar metabolism in the host. Sci. Rep. 2016, 6, 37434. [Google Scholar] [CrossRef]
- Saxena, A.; Hussain, A.; Parveen, F.; Ashfaque, M. Current status of metabolic engineering of microorganisms for bioethanol production by effective utilization of pentose sugars of lignocellulosic biomass. Microbiol. Res. 2023, 276, 127478. [Google Scholar] [CrossRef]
- Chutani, P.; Sharma, K.K. Concomitant production of xylanases and cellulases from Trichoderma longibrachiatum MDU-6 selected for the deinking of paper waste. Bioprocess Biosyst. Eng. 2016, 39, 747–758. [Google Scholar] [CrossRef]
- Leghlimi, H.; Zahia, M.; Boukhalfa-Lezzar, H.; Copinet, E.; Duchiron, F. Production and characterization of cellulolytic activities produced by Trichoderma longibrachiatum (GHL). Afr. J. Biotechnol. 2013, 12, 465–475. [Google Scholar] [CrossRef]
- Dong, M.; Wang, S.; Xu, F.; Xiao, G.; Bai, J.; Wang, J.; Sun, X. Integrative transcriptome and proteome analyses of Trichoderma longibrachiatum LC and its cellulase hyper-producing mutants generated by heavy ion mutagenesis reveal the key genes involved in cellulolytic enzymes regulation. Biotechnol. Biofuels Bioprod. 2022, 15, 63. [Google Scholar] [CrossRef]
- Dong, M.; Wang, S.; Xu, F.; Xiao, G.; Bai, J. Efficient utilization of waste paper as an inductive feedstock for simultaneous production of cellulase and xylanase by Trichoderma longiflorum. J. Clean. Prod. 2021, 308, 127287. [Google Scholar] [CrossRef]

| Sample | Dry Matter Loss (%) | Cellulose (%) | Hemicellulose (%) | Lignin (%) |
|---|---|---|---|---|
| Corn stover material | —— | 30.30 ± 1.41 | 24.91 ± 0.80 | 19.45 ± 0.42 |
| A. niger | 13.58 ± 0.69 | 29.71 ± 1.13 | 23.75 ± 0.95 | 19.80 ± 0.49 |
| A. oryzae | 11.06 ± 1.38 | 29.63 ± 0.71 | 24.11 ± 0.62 | 20.46 ± 0.10 |
| T. longibrachiatum | 15.97 ± 0.76 | 29.78 ± 1.31 | 24.56 ± 0.90 | 19.67 ± 0.41 |
| T. reesei | 13.95 ± 0.23 | 30.34 ± 1.52 | 24.68 ± 0.90 | 19.62 ± 0.48 |
| Sample | Cellulose (%) | Hemicellulose (%) | Lignin (%) |
|---|---|---|---|
| A. niger | 15.26 ± 1.45 ab | 17.62 ± 0.65 a | 12.04 ± 1.37 b |
| A. oryzae | 12.96 ± 2.21 c | 13.88 ± 2.16 c | 6.43 ± 2.34 c |
| T. longibrachiatum | 17.23 ± 1.65 a | 16.92 ± 3.18 ab | 14.84 ± 0.45 a |
| T. reesei | 13.86 ± 0.74 bc | 14.74 ± 0.91 bc | 13.23 ± 0.59 ab |
| Strain Category | HC (D/d) | Cellulolytic Index | Number of Strains |
|---|---|---|---|
| T. longibrachiatum parental strain | 2.081 ± 0.262 | 1.081 ± 0.262 | 659 |
| Positive mutants (HC > 20%) | >2.500 | >1.30 | 92 |
| Selected mutants for secondary screening(HC > 35%) | >2.800 | >1.50 | 19 |
| Negative mutants (HC < 20%) | <1.665 | <0.865 | 754 |
| Total strains screened | 1505 |
Disclaimer/Publisher’s Note: The statements, opinions and data contained in all publications are solely those of the individual author(s) and contributor(s) and not of MDPI and/or the editor(s). MDPI and/or the editor(s) disclaim responsibility for any injury to people or property resulting from any ideas, methods, instructions or products referred to in the content. |
© 2025 by the authors. Licensee MDPI, Basel, Switzerland. This article is an open access article distributed under the terms and conditions of the Creative Commons Attribution (CC BY) license (https://creativecommons.org/licenses/by/4.0/).
Share and Cite
Ren, F.; Wu, F.; Gao, L.; Jie, Y.; Wu, X. Proteomic and Mechanistic Insights into the Efficiency of Atmospheric and Room-Temperature Plasma Mutagenesis-Driven Bioconversion of Corn Stover by Trichoderma longibrachiatum. Fermentation 2025, 11, 181. https://doi.org/10.3390/fermentation11040181
Ren F, Wu F, Gao L, Jie Y, Wu X. Proteomic and Mechanistic Insights into the Efficiency of Atmospheric and Room-Temperature Plasma Mutagenesis-Driven Bioconversion of Corn Stover by Trichoderma longibrachiatum. Fermentation. 2025; 11(4):181. https://doi.org/10.3390/fermentation11040181
Chicago/Turabian StyleRen, Fengyun, Fan Wu, Le Gao, Yucheng Jie, and Xin Wu. 2025. "Proteomic and Mechanistic Insights into the Efficiency of Atmospheric and Room-Temperature Plasma Mutagenesis-Driven Bioconversion of Corn Stover by Trichoderma longibrachiatum" Fermentation 11, no. 4: 181. https://doi.org/10.3390/fermentation11040181
APA StyleRen, F., Wu, F., Gao, L., Jie, Y., & Wu, X. (2025). Proteomic and Mechanistic Insights into the Efficiency of Atmospheric and Room-Temperature Plasma Mutagenesis-Driven Bioconversion of Corn Stover by Trichoderma longibrachiatum. Fermentation, 11(4), 181. https://doi.org/10.3390/fermentation11040181

